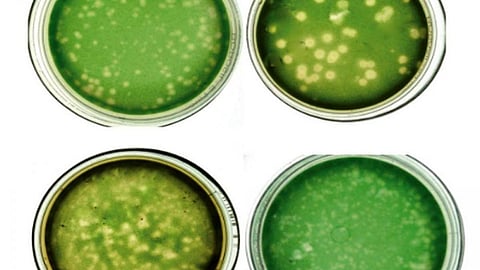
पृथक किए गए चार साइनोफेज वायरस

वैज्ञानिकों को मिले जलीय तंत्र में सन्तुलन बनाए रखने वाले वायरस
भारतीय वैज्ञानिकों ने विभिन्न जलीय पारिस्थितिकी तंत्र में पाए जाने वाले वायरसों की गणना की है। राष्ट्रीय समुद्र विज्ञान संस्थान (एनआईओ) और गोवा विश्वविद्यालय के वैज्ञानिकों द्वारा किए गए अध्ययन में ताजे पानी के जल-स्रोतों और समुद्री जल में वायरस की प्रचुर मात्रा मिली है।
शोधकर्ताओं ने ज्वारनदीमुख, झीलों और चावल के खेतों में इन जलीय वायरस की आबादी का आकलन किया है। चावल के खेतों में जलीय वायरस की प्रचुरता सबसे अधिक पायी गई है। चावल के खेतों के प्रति मिली लीटर पानी में सबसे अधिक लगभग 1.21 करोड़ वायरस मिले हैं। वहीं, झील के प्रति मिली लीटर पानी में 39 लाख और ज्वारनदीमुख के प्रति मिली लीटर जल में 21 लाख वायरस होने का अनुमान लगाया गया है।
शोधकर्ताओं को सिनेकोकोकस और सिनेकोसिस्टिस प्रजातियों के साइनोबैक्टीरिया (नील हरित शैवाल) को संक्रमित करने वाले चार साइनोफेज वायरसों को पृथक करने में भी सफलता मिली है। वायरसों की गणना के लिये समुद्री तट पर स्थित राज्य गोवा के जलीय निकायों को चुना गया था।
ज्वारनदीमुख समुद्र तट पर स्थित खारे जल के ऐसे स्रोत को कहते हैं, जिसमें एक या अधिक नदियाँ एवं झरने आकर मिलते हैं। इसका दूसरा छोर समुद्र से जुड़ा होता है। ज्वारनदीमुख में समुद्री और नदी के जल का मिश्रण होता है। ताजे और समुद्री जल में पाए जाने वाले नील हरित शैवाल प्रमुख प्राथमिक उत्पादक होते हैं और इन्हें संक्रमित करने वाले वायरस साइनोफेज कहलाते हैं।
समुद्री वातावरण वाले क्षेत्रों में जलीय वायरस कार्बन और दूसरे पोषक तत्व चक्रों के साथ-साथ सूक्ष्मजीवों को नियंत्रित करने में महत्वपूर्ण होते हैं। विभिन्न जल निकायों में अपशिष्ट बहाए जाने के कारण प्रदूषित जल में उपस्थित तत्व नील हरित शैवाल की वृद्धि को बढ़ावा देते हैं। इस कारण समुद्रों एवं दूसरे जल निकायों में नील हरित शैवाल के बायोमास में बढ़ोत्तरी होने लगती है और मछलियों तथा अन्य जलीय जीवों का जीवन खतरे में पड़ जाता है। इस बायोमास के बढ़ने से जल प्रबन्धन में भी गम्भीर समस्याएँ आती हैं।
गोवा विश्वविद्यालय के जैव प्रौद्योगिकी विभाग से जुड़े प्रमुख शोधकर्ता डॉ. संजीव सी. घादी ने इंडिया साइंस वायर को बताया,
“विभिन्न जल निकायों में वायरसों की आबादी उनके पोषकों के अनुपात में कम या ज्यादा होती रहती है। जलीय पारिस्थितिकी तंत्र में साइनोफेज साइनोबैक्टीरिया या नील हरित शैवाल की मृत्यु दर पर नियंत्रण रखते हैं और पारिस्थितिक संतुलन बनाए रखते हैं। कुछ क्षेत्रों में भरपूर पोषक तत्व मिलने पर साइनोबैक्टीरिया अधिक पनपने लगते हैं और बायोमास के रूप में पानी में फैल जाते हैं। इस तरह के फैलाव को नियंत्रित करने में साइनोफेज वायरस अहम भूमिका निभाते हैं।”
शोधकर्ताओं का कहना है कि सामान्य एवं जहरीले दोनों साइनोबैक्टीरिया रूपों के नियंत्रण में साइनोफेज वायरस जैविक एजेंट के रूप में उपयोग किए जा सकते हैं। इन वायरसों की मदद से जल-स्रोतों के प्रबन्धन और उनके सुधार में भी मदद मिल सकती है। साइनोबैक्टीरिया की समुदाय संरचना, उनकी प्रतिरोधी प्रक्रिया, बायोमास के निर्माण के प्रत्येक चरण पर साइनोफेज वायरस का पारिस्थितिकी पर प्रभाव और इन वायरस के वार्षिक जीवन चक्र जैसे अध्ययनों की आवश्यकता होगी। इस तरह के अध्ययनों से जल प्रबन्धन में साइनोफेज वायरस के व्यावहारिक उपयोग का आकलन करने में भी मदद मिल सकती है।
अध्ययन में शामिल शोधकर्ताओं की टीमअध्ययनकर्ताओं का मानना है कि जल निकायों में वायरस की गणना, अलगाव और गुणों के बारे में मिली जानकारियों से जलीय पारिस्थितिकी तंत्र और सिनेकोसिस्टिस जैसे जलीय वायरस के बारे में बेहतर समझ विकसित करने में यह अध्ययन सहायक हो सकता है।
शोधकर्ताओं के दल में संजीव सी. घादी के अलावा गोवा विश्वविद्यालय की जूडिथ मरियम नोरोन्हा और एआईओ के मंगेश गौंस एवं अमारा बेगम मुल्ला शामिल थे। यह अध्ययन शोध पत्रिका करंट साइंस के ताजा अंक में प्रकाशित किया गया है।
| TAGS |
| Cyanophages, Aquatic viruses, blue-green algae, Cyanobacteria |
लेटेस्ट अपडेट्स के लिए हमारे व्हाट्सऐप चैनल को फॉलो करें